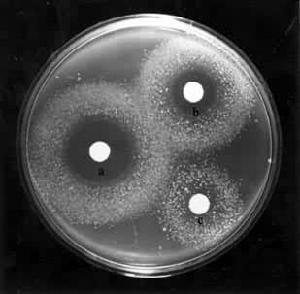
毒理遺傳學 毒理遺傳學

正文
或稱遺傳毒理學。用遺傳學方法研究環境因素對遺傳物質的損害及其毒理效應的遺傳學分支學科。環境因素造成的遺傳毒理效應包括三個方面:①突變形成,環境因素誘發生殖細胞的基因突變(點突變)和染色體畸變,從而造成子代遺傳性疾病發生頻率的增加,②癌形成,環境因素誘發體細胞基因突變或在親代遺傳的突變形成的背景上誘發體細胞突變,引起的體細胞惡性轉化為癌細胞的作用;③致畸效應,環境因素作用於發育中的胚胎細胞干擾了基因的正常作用,從而影響到胚胎細胞分化和器官系統的發育而導致畸胎的發生,也包括環境因素誘發親代生殖細胞的基因突變或染色體畸變引起畸胎的作用。致突變、致癌、致畸三者簡稱為毒理遺傳的三致效應。在套用方面毒理遺傳學的研究提供了許多迅速、準確、簡便的方法來檢測各種環境因素對遺傳結構的危害,以便採取措施,減少這些因素對人類的危害。簡史
1927年H.J.馬勒和1928年L.J.斯塔德勒用電離輻射誘發果蠅、玉米和大麥的基因突變。1951和1966年W.L.拉塞爾和B.M.卡塔納克分別用輻射和化學物質誘發了小鼠的基因突變,並且認為人類的遺傳性疾病也可能由環境因素引起。1968年J.E.克利弗發現人類的著色性乾皮病病人的皮膚很易光化癌化,並且指出這是由於先天缺乏修復為紫外線誘發的DNA損傷的能力所致,並明確指出了癌症、環境因素和DNA損傷修復之間的關係。此後人們才認識到工業發達後某些物質的擴散是對人類遺傳的潛在危害,毒理遺傳學於是應運而生。1973年B.N.艾姆斯首創一種用細菌的回覆突變作為觀察指標的快速簡便的檢測誘變物質的方法,並且發現大約90%的致癌物質具有誘變作用。研究致突變、致癌和致畸三者之間的關係以及通過檢測誘變作用來判斷藥物的致癌和致畸的可能性已成為毒理遺傳學的理論探討和實際套用方面的重要課題。致突變、致畸、致癌物質的檢測方法
對各種化學物質的致癌和在胚胎髮育過程中的致畸效應的檢測,早期的方法是用待測化學物質餵飼、注射動物或塗布在動物皮膚上,然後觀查動物是否因此而患腫瘤或出現畸胎等。這種方法往往要用幾種動物並重複試驗才能得出可靠的結論,而且費用大,時間長。絕大部分致癌物質具有誘變作用這一發現促使人們考慮用簡便的測試方法來代替動物試驗。現在一般都採用細菌或離體培養的哺乳動物和人類體細胞為測試對象,主要的方法有:以基因突變為指標的檢測法 在許多檢測方法中以艾姆斯測驗最有效。它用鼠傷寒沙門氏菌的組氨酸缺陷型(不能在沒有組氨酸的培養基上生長的突變型)菌株為測試對象,如果菌株用某待測化學物質處理後能在沒有組氨酸的培養基上形成菌落,就說明發生了回復突變(圖1)。
根據菌落出現的數目就可以估算出該物質誘變能力的強弱。套用哺乳動物肝臟微粒體酶系(S9)作為活化系統,使待測物質先行活化,用這一模擬活體內代謝狀況的措施進一步提高了檢測的準確性。 以染色體為指標的方法 除用經典的染色體畸變分析方法外,近年還發展了下列方法:①微核測試法,以骨髓細胞或外周血淋巴細胞中微核的數量變化為指標的測試方法。各類染色體畸變中除易位、倒位或互換外一般常伴有無著絲粒斷片的產生,這種斷片在間期細胞的細胞質中呈現為一種圓形或橢圓形的結構──微核。因此微核出現的數目可作為染色體畸變的指標。②姐妹染色單體互換測試法,在處於增殖狀態的細胞培養物中添加5-溴脫氧尿嘧啶核苷(BrdU),BrdU在細胞分裂的DNA合成期(S期)的DNA半保留複製過程中參入到新合成的 DNA子鏈中,在BrdU持續存在兩個細胞周期的情況下用吉姆薩染料對進入有絲分裂期 M期的細胞進行染色。由於在兩個姐妹染色單體的一個單體中 BrdU參入了一個DNA單鏈,而在另一個單體中則參入了兩個單鏈,因此兩個單體間的染色便出現了色差(圖2)。如果兩個染色單體呈現對應的染色不連續部分,則說明姐妹染色單體間發生了互換。在相對恆定的培養條件下,每個細胞出現的姐妹染色單體互換(SCE)次數也是相對恆定的,當培養物中再添加誘變劑,就可以看到SCE顯著增加(圖3)。用細胞中的 SCE率來檢測環境誘變劑,是一個簡單、快速、靈敏的方法。該法可以套用離體培養的細胞為材料,也可套用活體細胞為材料,在離體檢驗中可以模擬體內情況先用微粒體酶活化系統活化待檢物以進一步提高檢測的可靠性。
毒理遺傳學
毒理遺傳學其他還有 DNA損傷修復的檢測和離體培養細胞惡性轉化試驗等檢測方法。
套用
環境因子的監測 據估計目前城市居民接觸的化學物質有6萬或7萬種以上,隨著工業的發展,每年又有上千種新的化學物質進入人類社會。用上述一系列方法結合果蠅和哺乳動物細胞的點突變(見基因突變)測驗可對某一種可疑物質的遺傳危害做出判斷。職業病的防治 定期檢查接觸有毒害物質或放射性物質的工作者的外周血、尿、糞便和精液等,以便監測有害物質的遺傳毒理效應。通過這些工作可以探索職業性癌症的病因,評價工業毒物的遺傳危害,為制定工業毒物的最高允許濃度提供依據。
藥物的臨床過渡 一種新的藥物在臨床套用前除了作一般毒理學的檢測外,常需作遺傳毒理的檢測以便為安全用藥提供依據。
目前的測試方法還不能完全排除把沒有遺傳毒性的物質誤認為有毒(假陽性)和把有毒性的物質誤認為無毒(假陰性),因此如何進一步設計採用性細胞為材料等方法,消除離體和活體測試結果的差別,提高精確度,研究各種化學物質相互作用關係和作用時相對遺傳效應的影響等,都是毒理遺傳學面臨的研究課題。通過這些研究也必將加深對毒理遺傳三致效應化學機制的認識。
參考書目
David Brusick,Principles of Genetic Toxicology,Plenum Press,New York,1980.